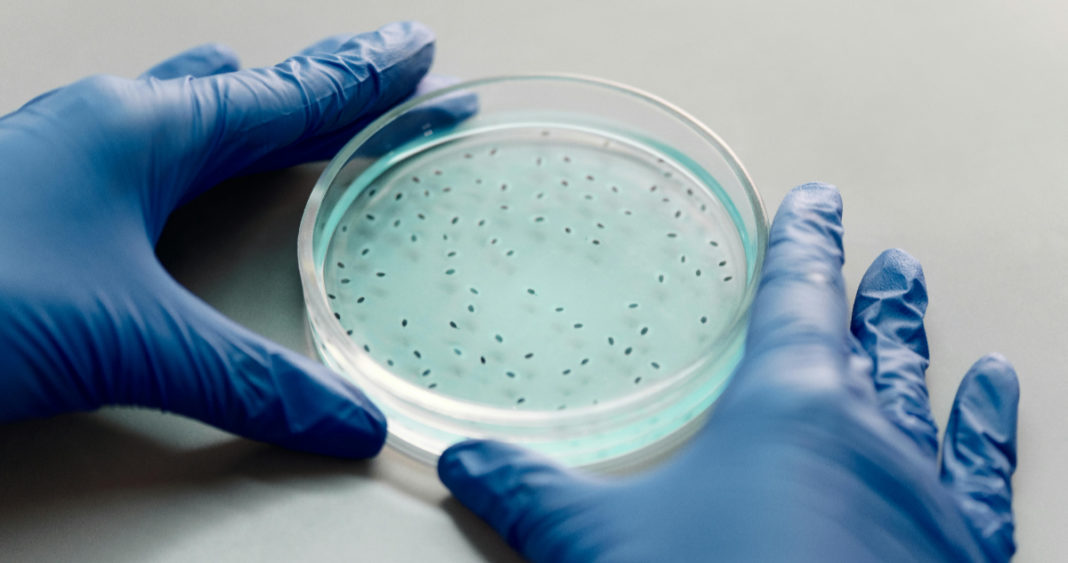
La Ascensión Científica de China: Implicaciones Estratégicas para Occidente

La frase «Scientia potestas est» (El conocimiento es poder), acuñada por el filósofo inglés Francis Bacon, sigue siendo tan válida hoy como lo fue en el siglo XVI. Sin embargo, el mapa mundial de la investigación científica está experimentando un cambio profundo, y el ascenso de China como potencia científica global tiene implicaciones estratégicas significativas para Occidente.
Según un estudio publicado en la revista Proceedings of the National Academy of Sciences (PNAS), en 2023 los científicos chinos lideraron casi la mitad de las investigaciones conjuntas con colegas estadounidenses, un hito histórico que refleja el vertiginoso avance de China en el campo de la ciencia. Este cambio de poder se mide ahora con nuevos parámetros, más allá de los premios Nobel o la cantidad de publicaciones.
El Liderazgo Científico de China
Según el informe más reciente del G20 sobre investigación e innovación, China publicó casi 900.000 artículos científicos en 2023, tres veces más que en 2015. Además, en el prestigioso Nature Index, que evalúa las revistas científicas y médicas más importantes, China ya ha superado a Estados Unidos. De hecho, entre las diez instituciones con más publicaciones en ese índice, siete son chinas, mientras que el MIT, el prestigioso Instituto Tecnológico de Massachusetts, aparece recién en el décimo lugar.
Este avance se debe a una estrategia deliberada de Pekín, que ha hecho de la ciencia el corazón de su plan de desarrollo. China ha abierto sus instituciones a la cooperación internacional, fomentando activamente el intercambio global. Además, a través de su iniciativa BRI (Belt and Road Initiative) de infraestructura y desarrollo, invierte miles de millones en educación y tecnología para atraer talento extranjero y consolidar lazos académicos.
Fortalezas y Límites del Modelo Chino
La velocidad, la inversión masiva y las redes coordinadas son las grandes ventajas del sistema científico chino. En áreas como ingeniería, electrónica, física, química y ciencia de materiales, los resultados son notables. Sin embargo, el control centralizado también impone límites, ya que China carece aún de innovaciones disruptivas y de la independencia que caracteriza a la ciencia occidental. En ese sentido, Estados Unidos, con su cultura descentralizada e impulsada por empresas, sigue teniendo ventaja.
Además, la cooperación internacional se ha vuelto más difícil, ya que Estados Unidos y Europa consideran a China un rival estratégico, y las tensiones geopolíticas y económicas de los últimos meses no ayudan.
La Carrera por la Inteligencia Artificial
En el campo de la inteligencia artificial (IA), Estados Unidos mantiene el liderazgo por ahora, pero China avanza con pasos firmes. Su modelo lingüístico Deepseek demuestra la rapidez y el bajo costo con que sus tecnologías pueden llegar al mercado. Mientras tanto, Harvard continúa siendo un referente, pero las academias chinas acortan distancias a gran velocidad.
El Impacto Global: Un Nuevo Orden Científico
El avance del gigante asiático está reconfigurando el equilibrio económico y geopolítico mundial. China ya marca parte de la agenda global de investigación, mientras que Europa pierde terreno en la carrera por las tecnologías del futuro. Este crecimiento coincide con una etapa de debilidad en Occidente, donde la investigación estadounidense sufre recortes, polarización política y fuga de talentos.
Para mantener su relevancia, Europa tendría que apostar decididamente por una política científica común, más allá de los intereses nacionales. Su diversidad de lenguas, culturas y tradiciones puede ser una fuente de innovación, no una debilidad.